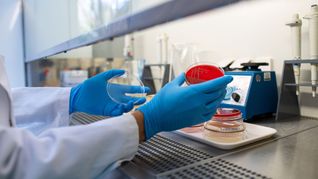
Die Zahl der registrierten Ehec-Infektionen in Mecklenburg-Vorpommern hat sich auf 17 erhöht. (Illustration)

Einige besonders augenfällige Auswirkungen der globalen Erwärmung auf das Erdsystem können die meisten Menschen aufzählen: So schmelzen die Polkappen und der Permafrostboden taut. Dass sich die Atlantische Umwälzbewegung – abgekürzt Amoc (Atlantic Meridional Overturning Circulation) – abschwächt, ist hingegen weit weniger bekannt. Dabei sind die vermuteten Folgen noch sehr viel bedrohlicher.
Besonders dramatisch wäre die Situation, sollte dieses Strömungssystem ...
Als Digital Abonnent (E-Paper) anmelden und kostenfrei weiterlesen.
Als SZ/BZ Premium Abonnent (gedruckt) anmelden oder registrieren und kostenfrei weiterlesen.
Bei Fragen wenden Sie sich bitte an unseren Kundenservice unter 07031 / 862-0